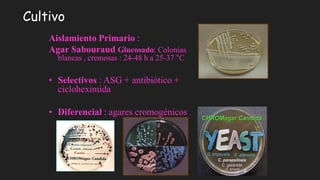
Cultivo
Aislamiento Primario :
Agar Sabouraud Glucosado: Colonias
blancas , cremosas : 24-48 h a 25-37 °C
• Selectivos : ASG + antibiótico +
cicloheximida
• Diferencial : agares cromogénicos .
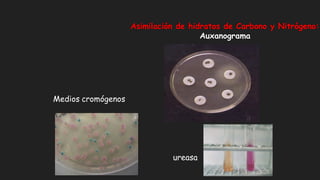
Asimilación de hidratos de Carbono y Nitrógeno:
Auxanograma
Medios cromógenos
ureasa

El documento describe las micosis oportunistas causadas por hongos. Estas infecciones han aumentado considerablemente en las últimas décadas en personas sometidas a trasplantes de órganos, cirugía mayor, VIH/SIDA o tratamientos inmunosupresores. Los agentes más comunes son Candida albicans, Cryptococcus neoformans y Aspergillus fumigatus. Algunos de estos hongos muestran resistencia a los tratamientos antifúngicos convencionales y se requieren alternativas.